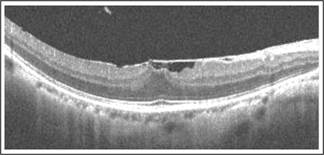
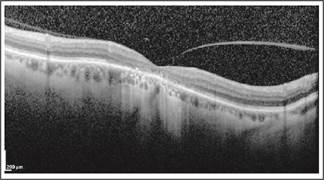
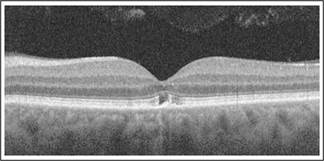

|
U |
nexplained visual loss (UVL) is defined as reduced vision without any identifiable physical cause.1 It is a common problem amongst patients presenting to ophthalmic care services2 and poses anxiety to both the doctor and patient alike. Many algorithms have been defined and approaches to UVL have been suggested but the problem often remains unresolved.3,4
Published literature has emphasized the importance of a thorough
ocular exam as an integral part of solving UVL.5 Uncommon and subtle
problems that should be kept in mind when faced with UVL have also been enumerated
by studies.6 Studies have been done regarding the use of
investigative tools like Electroretinogram and visual evoked potential to
decipher the cause of UVL.7 But in spite of all of the above,
patients diagnosis remains a dilemma and it is common practice then to refer
such patient to a neurologist in the blind hope that neuroimaging of the optic
pathway may reveal an abnormality. Needless to say, this also often proves a
futile exercise at the expense of the patient or his provider. When all else
fails, the patient with UVL may even be referred to a psychiatrist on an
assumed diagnosis of non organic
visual loss which adds further to the patients distress.
OCT has established itself as a novel noninvasive retinal imaging modality. It has been likened to an “in vivo optical biopsy” providing highly magnified high resolution images of the vitreous, retina and even choroid. We intended to study if OCT could help us decipher a cause in a patient with UVL. After extensive search of literature we were unable to find a single study with the same objective.
MATERIAL AND METHODS
We conducted this study at Amanat Eye Hospital, Rawalpindi in a period of one year (from Oct 2014 to Oct 2015). Approval was taken from the hospitals ethical committee. A retrospective review of cases of UVL was done from the diagnostic register. We based the diagnosis UVL on an apparently normal ocular (including fundus exam) or one in which the fundus findings were too subtle to explain the extent of visual loss (e.g. a dull foveal reflex). Whenever, possible the referring consultant was contacted to discuss the case. Then the findings of OCT were reviewed.
RESULTS
83 cases of UVL were identified from our records and included in this study. 34 patients were referred from within the hospital and 49 were referred from various ophthalmic set ups in the region.

Fig. 1: Vitreomacular traction.
Of the 83 patients labeled UVL, OCT detected an organic cause to the visual loss in 37. The male: female was 17:20. The mean age in years was 50.10 ± 17.11yrs. The minimum age was 04yrs and maximum age was 80yrs. The various pathologies detected on OCT, along with the demographic data are presented in Table 1 and shown in Figures 1-10. 46 patients of UVL had normal OCT scans.

Fig. 2: Stage 1b macular hole. Dehiscence of the neurosensory retina.
Table 1: Frequency of pathologies detected on SD OCT. VMTS: vitreomacular traction synrdrome, ERM: Epiretinal membrane, IJFT: Idiopathic juxtafoveal telangiectasia, JXLR: 004 Auvenile X linked retinoschisis, AMN: Acute macular neuroretinopathy.
|
No. |
Pathology |
n |
% |
Mean Age (yrs) (SD) |
M:F |
|
1. |
VMTS |
10 |
27.03 |
50.24 ±5.21 |
4:6 |
|
2. |
ERM |
05 |
13.51 |
68.41±4.63 |
2:3 |
|
3. |
Macular hole |
04 |
10.81 |
74.54±5.82 |
2:2 |
|
4. |
Lamellar hole |
02 |
5.40 |
61.0±8.91 |
0:2 |
|
5. |
IJFT |
03 |
8.10 |
56.70±3.24 |
1:2 |
|
6. |
Cone dystrophy |
04 |
10.81 |
5.93±2.32 |
2:2 |
|
JXLR |
01 |
2.7 |
4.00 |
1M |
|
|
8. |
Retinal arteritis |
01 |
2.7 |
34.00 |
1M |
|
9. |
AMN |
01 |
2.7 |
36.00 |
1F |
|
10. |
Solar maculopathy |
01 |
2.7 |
32.00 |
1M |
|
11. |
Foveal atrophy |
05 |
13.51 |
57.33±4.36 |
3:2 |
Fig. 3: Early Epiretinal membrane. Lack of surface wrinkling makes this difficult to see with 90D.

Fig. 4: Lamellar hole secondary to epiretinal membrane and chronic cystoid foveal edema

Fig. 5: IJFT type 2. Right eye showing atrophic cysts at the fovea and a gap in the IS/OS layer
Fig. 6: Cone dystrophy shows selective outer foveal degradation with loss of photoreceptors and back scattering of the light signal.
DISCUSSION
OCT has allowed better in vivo visualization of macular anatomy increasing our capability to evaluate the retina at a resolution that was unprecedented by conventional retinal imaging methods. By utilizing this property we have been able to reach a diagnosis in almost 45% of patients in our study group and have therefore attempted to justify its use in UVL with apparently normal fundus.

Fig. 7: Juvenile X- linked Retinoschisis. Intraretinal split at the fovea
Fig. 8: Retinal Arteritis Right eye OCT and corresponding FFA. The left eye was normal.
![]()

Fig. 9: Acute macular neuroretinopathy hyper reflectivity at the ONL/OPL junction (yellow arrow).
Fig. 10: Solar Retinopathy. Selective subfoveal outer retinal degradation
For this retrospective review we chose to work on the Heidelberg Spectralis (SD OCT with EDI mode). It is a state of the art OCT device with a resolution of 5 microns and the highest coefficient of variability yet.
Waldstein et al8 compared the Spectralis to swept source Topcon DRI OCT 1 and Cirrus OCT (SD OCT without EDI mode). He states that the Heidelberg Spectralis has a greater penetration depth and visibility compared to Cirrus and equal to Topcon SS OCT system. In regard to contrast levels of deep choroidal vessels Spectralis gave superior results compared to both Topcon and Cirrus OCT. Such characteristics, we predicted, would help in evaluation of our patients with UVL.
Vitreomacular traction syndrome was amongst the most common causes detected on OCT that could explain UVL. SD OCT enables us to study the posterior vitreous and the intricate relationship it has with the inner retina. We are easily able to differentiate vitreomacular adhesion from vitreoschisis and vitreomacular traction which is not clinically visible. Also the 3-D image reconstruction feature can help identify surgical plans improve pre operative planning and therefore optimize surgical outcomes. Koizumi et al9 performed three dimensional scanning of VMTS and demonstrated that VMTS is frequently associated with undiagnosed epiretinal membranes that can negatively impact vision and the surgical ease with which vitreous traction can be relieved per operatively. We also observe ERM in 4 of our cases of VMTS.
Important to note is that 07 of our patients with VMTS were diabetics without retinopathy. VMT is essential to diagnose in patients with diabetes. A study vitreoretinal interaction was studies in eyes with DME established that DME is aggravated by abnormal VR interaction.9
Macular holes are a consequence of centrifugal displacement of cone receptors to form a dehiscence at the umbo. Abnormal vitreofoveolar interaction is said to lead to this pathology. Clinically early macular holes Stage 1 and full thickness macular holes less than 200 microns are difficult to detect.
Early macular holes may be seen on OCT as a schitic cavity at the level of the outer plexiform layer and the outer nuclear layer10. This then extends to involve the IS/OS junction and the layer representing the interaction of the cone outer segments with the RPE.11
Lamellar hole can arise secondary to chronic cystoid intraretinal edema. It poses a challenge when cystoid thickening is adequately treated and, as a consequence, the retinal thickness improves but with no subsequent improvement in vision. Enface visualization of macular hole makes differentiation from lamellar hole and pseudohole difficult (Figure 04). All show central macular window defect hyperfluorescence on FFA. OCT helps to clearly distinguish these conditions from one another12. Furthermore and more recently a mathematical analogue based on OCT of premacular hole pathology has been designed to predict the risk of full thickness macular hole formation in fellow eyes of patients with FTMH.13 Additionally, using OCT we can go beyond diagnosis. In evaluation of macular holes, it has been established that the magnitude of the defect of Ellipsoid zone both before and after surgery can impact the visual prognosis.14
Epiretinal membrane is a fibrocellular membrane growing over the retina. In advanced stages it can cause macular pucker which is easily visible. But in early stages it may be missed especially since the age at which a patient is prone to develop epiretinal membrane is also the age at which lenticular changes become advance and cause problems in visualizing the macula15. Surgery for this condition was previously advised after the vision had deteriorated more than 6/12 (20/40). However, OCT had demonstrated that macular thickening and IS/OS distortion much before this stage is reached. These features on OCT can compromise the visual results of treatment.
Idiopathic juxtafoveal telangiectasia can cause obscure visual symptoms. The fundus exam is initially normal. Even on FFA, early lesions are not delineated as clear telangiectatic vessels but rather as an indiscrete mild late leakage abutting the foveal area. However, on OCT the telltale sign of this disorder is a disruption of the IS/OS segment of the photoreceptor, atrophic cystoid changes at the fovea without exudation or thickening and a characteristic retinal ILM drape over the cysts.
4 cases were identified in which children were reported to have
decrease vision with an apparently normal fundus. Color vision tests were
consistently abnormal in all cases (Figure 06). A diagnosis of cone dystrophy
was made. Cone dystrophy is a hereditary disorder. Most cases are sporadic. The
most frequent established pattern is AD but AR and XL cases have also been
reported. In our set up owing to a high frequency of consanguineous marriages,
hereditary retinal dystrophies are seen with increasing prevalence than
reported internationally with crowding within the same family. These children
present with more severe forms and sometimes atypical forms of this disease. 4 major categories of
SD – OCT findings have been defined by Cho,16 based on the status
of the ellipsoid portion of the photoreceptor inner segment (ISe), outer
segment (OS) contact cylinder, and retinal pigment epithelium (RPE) layer. The more subtly presenting subtypes will
present with an essentially normal fundus and the child would be symptomatic.
06 years old male child was included. The visual acuity was 6/24 in both eyes with no significant refractive error and a subtle yet undiagnosed maculopathy. On OCT both eyes were showing a similar picture (figure. 08). These findings were consistent with Juvenile X-linked Retinoschisis.
Differential diagnosis included cystoid macular edema associated with Retinitis Pigmentosa.16 Important to note is that both these conditions are angiographically silent (show no leakage on FFA). Incidence of JXLR is estimated at 1:5000. These features have been discovered on OCT by other investigators who also state their presence in an apparently normal fundus.17
In a 35 years old female, fundus examination revealed subtle tear drop shaped retinal lesions pointing to the center of the fovea. The OCT revealed corresponding intraretinal hyper reflectivity at the ONL/OPL junction (Figure. 09) characteristic of acute macular neuroretinopathy. Hanson18 states in his study that Advanced Optics scanning laser ophthalmoscope is a better tool than OCT to observe changes of AMN. However, we were still able with OCT to diagnose and counsel our patient which proved fruitful.
Of 05 cases of selected foveal atrophy, the cause
was not found19. However, even in these cases we were able to
explain the loss of vision and could counsel the patient accordingly.
In light of the above, it seems important to consider OCT in cases of unexplained visual loss even if apparently the fundus is normal.
It is prudent to note that more than 50% of patients with UVL, we were unable to find any abnormality on OCT. This is one limitation of our study. We would have liked to follow up on patients who did not have any abnormality on OCT, so further stats could be provided as to what diagnosis was eventually reached. However, more than half of our patients were referred from other set ups in the region and it was not always possible to maintain adequate follow up for this purpose.
As mentioned above, after extensive search of literature we were unable to find a single published study with the same objective. We recommend based on our study, that OCT be advised in all patients in whom, after a thorough and detailed clinical ophthalmic examination, no cause could be found. We suggest that this valueable investigation be taken advantage of before such a patient is referred to other specialties such as neurology or psychiatry because once it is stated that ophthalmic exam is ‘normal’, he/she is unlikely to return to ophthalmic set ups. This will entail further anxieties as well as costs to undergo further investigations like neuroimaging etc.
By using SD-OCT, we were able to help almost half of the patients with UVL and were able to give them a definitive diagnosis. They were then subsequently counseled about their disease and referred appropriately for treatment where possible. This not only served to alleviate their anxieties but also prevented unnecessary referrals to physicians, psychiatrist and other specialists.
CONCLUSION
OCT was able to identify various retinal pathologies in patients with UVL that was missed on fundus exam. With its help, a wide fraction of patients labeled with UVL were excluded from this obscure diagnosis.
Author’s Affiliation
Dr. Hina Khan
Consultant Ophthalmologist
Amanat Eye Hospital
Rawalpindi
Dr. Aamir Asrar
Chief Consultant Ophthalmologist
Amanat Eye Hospital
Rawalpindi
Dr. Muhammad Siddique
Assistant Professor
Sheikh Zayed Hospital
Rahim Yar Khan
Sumaira Amir Joya
Optometrist and Orthoptist
Amanat Eye Hospital
Rawalpindi
Maria Akhtar
Optometrist
Amanat Eye Hospital
Rawalpindi
Role of Authors
Dr. Hina Khan
Collection of data, interpretation of OCT scans and writes up of article.
Dr. Aamir Asrar
Sharing of data and interpretation of OCT scans
Dr. Muhammad Siddique
Sharing and compilation of data
Sumaira Amir Joya
Data analysis
Maria Akhtar
Data Analysis
REFERENCES
1. Griffiths PG, Ali N. Medically unexplained visual loss in adult patients. Curr Opin Neurol. 2009 Feb; 22 (1): 41-5.
2. Kiernan DF, Mieler WF, and Hariprasad SM. Spectral – domain optical coherence tomography: a comparison of modern high – resolution retinal imaging systems. American Journal of Ophthalmology, vol. 149, no. 1, pp. 18.e2–31.e2, 2010.
3. O'Leary ÉD, McNeillis B, Aybek S, Riordan – Eva P, David AS. Medically unexplained visual loss in a specialist clinic: a retrospective case – control comparison. J Neurol Sci. 2016 Feb 15; 361: 272-6.
4. Brown RJ. Introduction to the special issue on medically unexplained symptoms: background and future directions. Clin Psychol Rev. 2007 Oct; 27 (7): 769-80.
5. Eminson DM. Medically unexplained symptoms in children and adolescents. Clin Psychol Rev. 2007 Oct; 27 (7): 855-71.
6. Acosta PC, Trobe JD, Shuster JJ, Krischer JP. Diagnostic strategies in the management of unexplained visual loss. A cost-benefit analysis. Med Decis Making, 1981; 1 (2): 125-44.
7. Renner AB, Kellner U, Tillack H, Kraus H, Foerster MH. Recording of both VEP and multifocal ERG for evaluation of unexplained visual loss electrophysiology in unexplained visual loss. Doc Ophthalmol. 2005 Nov; 111 (3): 149-57.
8. Waldstein SM, Faatz H, Szimacsek M, Glodan AM, Podkowinski D, Montuoro A, Simader C et al. Comparison of penetration depth in choroidal imaging using swept source vs. spectral domain optical coherence tomography. Eye, 2015; 29: 409-415.
9. Ophir A, Martinez MR, Mosqueda P, Trevino A. Vitreous traction and epiretinal membranes in diabetic macular oedema using spectral-domain optical coherence tomography. Eye, 2010 Oct; 24 (10): 1545-53.
10. Koizumi H, Spaide RF, Fisher YL, Freund KB, Klancnik JM Jr, Yannuzzi LA. Three – dimensional evaluation of vitreomacular traction and epiretinal membrane using spectral – domain optical coherence tomography. Am J Ophthalmol. 2008 Mar; 145 (3): 509-517.
11. García – Layana A, García – Arumí J, Ruiz – Moreno JM, Arias – Barquet L, Cabrera – López F, Figueroa MS. A Review of Current Management of Vitreomacular Traction and Macular Hole. J. Ophthalmol. 2015; 2015 (809640): 14.
12. Barak Y, Ihnen MA, Schaal S. Spectral Domain Optical Coherence Tomography in the Diagnosis and Management of Vitreoretinal Interface Pathologies. J. Ophthalmol. 2012; 2012 (876472): 7.
13. Barak Y, Sherman MP, Schaal S. Mathematical analysis of specific anatomic foveal configurations predisposing to the formation of macular holes. Invest Ophthalmol Vis Sci. 2011; 52 (11): 8266–8270.
14. Chang LK, Koizumi H, Spaide RF. Disruption of the photoreceptor inner segment – outer segment junction in eyes with macular holes. Retin. 2008; 28 (7): 969–975.
15. Kampik A. Pathology of epiretinal membrane, idiopathic macular hole, and vitreomacular traction syndrome. Retina, 2003; 32 (2): 194–199.
16. Cho SC, Woo SJ, Park KH, Hwang JM. Morphologic characteristics of the outer retina in cone dystrophy on spectral – domain optical coherence tomography. Korean J Ophthalmol. 2013 Feb; 27 (1): 19-27.
17. Brockhurst RJ, Sandberg MA. Optical coherence tomography findings in occult macular dystrophy. Am J Ophthalmol. 2007 Mar; 143 (3): 516-8.
18. Hansen SO, Cooper RF, Dubra A, Carroll J, Weinberg DV. Selective Cone Photoreceptor Injury in Acute Macular Neuroretinopathy. Retina, 2013 Sep; 33 (8): 1650–1658.
19. Greenberg JP, Sherman J, Zweifel SA, Chen RWS, Duncker T, Kohl S, Baumann B, Wissinger B, Yannuzzi LA, Tsang SH. Spectral-Domain Optical Coherence Tomography Staging and Autofluorescence Imaging in Achromatopsia. JAMA Ophthalmol. 2014 Apr 1; 132(4): 437–445.
20. Sundaram V, Wilde C, Aboshiha J, Cowing J, Han C, Langlo CS, Chana R, Davidson AE, Sergouniotis PI, Bainbridge JW, Ali RR, Dubra A, Rubin G, Webster AR, Moore AT, Nardini M, Carroll J, Michaelides M. Retinal structure and function in achromatopsia: implications for gene therapy. Ophthalmology, 2014 Jan; 121 (1): 234-45.
